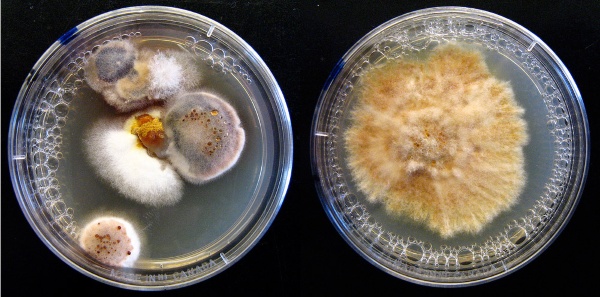
Môi trường PDA sử dụng phổ biến trong nuôi cấy nấm mốc và nấm men trong phòng thí nghiệm vi sinh

Lựa chọn môi trường nuôi cấy phù hợp đóng vai trò quyết định đến sự thành công của quá trình phân lập và định danh. Trong số hàng trăm loại môi trường tổng hợp và hữu cơ, môi trường PDA nổi lên như một “tiêu chuẩn vàng”, đặc biệt là đối với các nghiên cứu về nấm men và nấm mốc. Bài viết dưới đây, MT phân tích cụ thể cấu tạo, ưu điểm và ứng dụng của môi trường PDA trong nghiên cứu lẫn sản xuất sinh học.
Môi trường PDA là môi trường gì?
Môi trường PDA (Potato Dextrose Agar) là một loại môi trường nuôi cấy rắn phổ biến, được sử dụng chủ yếu để nuôi cấy và phân lập nấm men, nấm mốc và một số vi sinh vật khác. Đây là môi trường giàu dinh dưỡng, được thiết kế nhằm tạo điều kiện tối ưu cho sự phát triển của các vi sinh vật ưa đường.
PDA được tạo thành từ ba thành phần chính: dịch chiết khoai tây (potato infusion), đường dextrose và agar. Sự kết hợp này cung cấp nguồn carbon dồi dào, vitamin và khoáng chất cần thiết cho sự sinh trưởng của vi sinh vật.
Đặc điểm nổi bật của môi trường PDA là có độ pH hơi axit (thường khoảng 5.6), giúp ức chế sự phát triển của vi khuẩn và tạo điều kiện thuận lợi cho nấm phát triển mạnh. Chính vì vậy, PDA thường được sử dụng trong các phòng thí nghiệm vi sinh, viện nghiên cứu, cũng như trong ngành thực phẩm và dược phẩm.

Ưu điểm của môi trường PDA
Sự phổ biến của môi trường PDA trong các phòng thí nghiệm trên toàn thế giới không phải là ngẫu nhiên. So với các loại môi trường chuyên biệt khác, PDA sở hữu nhiều ưu điểm vượt trội:
- Tính phổ dụng cao: PDA có khả năng hỗ trợ sự phát triển của hầu hết các loại nấm men và nấm mốc phổ biến.
- Kích thích hình thành đặc điểm hình thái: PDA cung cấp nguồn dinh dưỡng giúp nấm sản sinh sắc tố (pigmentation) và cấu trúc bào tử đặc trưng, hỗ trợ đắc lực cho công tác định danh bằng mắt thường và kính hiển vi.
- Dễ dàng điều chỉnh độ pH: Nấm thường phát triển tốt trong môi trường hơi acid. Môi trường PDA rất dễ dàng điều chỉnh pH xuống khoảng 3.5 ± 0.1 bằng cách bổ sung acid tartaric hoặc acid lactic sau khi hấp khử trùng.
- Chi phí thấp và dễ chuẩn bị: Thành phần của PDA cực kỳ đơn giản. Nếu không sử dụng các loại bột pha sẵn từ các hãng hóa chất, nhà nghiên cứu hoàn toàn có thể tự chế biến từ khoai tây tươi và đường thương mại với chi phí rất rẻ.
- Độ bền và tính ổn định: Môi trường PDA có thể bảo quản được khá lâu trong tủ lạnh mà không bị biến chất nhanh chóng, giúp tiết kiệm thời gian chuẩn bị cho các thí nghiệm quy mô lớn.

Các thành phần chính của môi trường PDA
Môi trường PDA được cấu thành từ các thành phần cơ bản nhưng mang lại hiệu quả dinh dưỡng tối ưu cho sự phát triển của nấm men và nấm mốc. Dưới đây là các thành phần chính:
- Dịch chiết khoai tây: Là nguồn cung cấp dinh dưỡng tự nhiên giàu vitamin (đặc biệt là nhóm B), khoáng chất và các hợp chất hữu cơ. Thành phần này giúp kích thích sự phát triển mạnh mẽ của nấm, đồng thời hỗ trợ hình thành khuẩn lạc rõ nét, đặc trưng.
- Dextrose (glucose): Đóng vai trò là nguồn carbon dễ hấp thu, cung cấp năng lượng trực tiếp cho quá trình trao đổi chất và sinh trưởng của vi sinh vật. Hàm lượng dextrose được kiểm soát để đảm bảo tốc độ phát triển ổn định, tránh hiện tượng phát triển quá mức.
- Agar: Là chất tạo đông có nguồn gốc từ tảo biển, giúp môi trường có dạng rắn với bề mặt ổn định. Agar không bị vi sinh vật phân hủy trong điều kiện nuôi cấy thông thường, giúp thuận lợi cho việc phân lập, cấy truyền và quan sát khuẩn lạc.
Ngoài ra, có thể bổ sung kháng sinh hoặc điều chỉnh pH tùy mục đích sử dụng.
Đọc thêm bài viết:
Môi trường MS trong nuôi cấy mô thực vật

Ứng dụng của môi trường PDA
Môi trường PDA được ứng dụng rộng rãi trong nhiều lĩnh vực nhờ khả năng nuôi cấy nấm hiệu quả, dễ quan sát và tính linh hoạt cao. Đây là môi trường tiêu chuẩn trong cả nghiên cứu lẫn sản xuất.
- Trong nghiên cứu vi sinh: Sử dụng để phân lập, nuôi cấy và quan sát đặc điểm hình thái của nấm mốc, nấm men từ các mẫu như đất, nước, không khí. PDA giúp nhận diện chủng thông qua màu sắc, cấu trúc và tốc độ phát triển khuẩn lạc.
- Trong ngành thực phẩm: Dùng để kiểm tra và phát hiện nấm gây hư hỏng trong nguyên liệu và thành phẩm (bánh, trái cây, đồ uống…). Từ đó hỗ trợ kiểm soát chất lượng và kéo dài thời hạn bảo quản.
- Trong dược phẩm – công nghệ sinh học: Ứng dụng trong kiểm tra độ nhiễm nấm của nguyên liệu, bán thành phẩm và sản phẩm cuối. Ngoài ra, PDA còn được dùng để nuôi cấy các chủng nấm phục vụ sản xuất enzyme, kháng sinh hoặc hoạt chất sinh học.
- Trong nông nghiệp: Hỗ trợ phân lập và nghiên cứu các loại nấm gây bệnh trên cây trồng, từ đó giúp chẩn đoán và đề xuất biện pháp phòng trừ. Đồng thời, PDA cũng được dùng để nuôi cấy nấm có lợi trong chế phẩm sinh học.
- Trong đào tạo và kiểm nghiệm: Là môi trường cơ bản trong phòng thí nghiệm của các trường đại học, viện nghiên cứu, giúp sinh viên và kỹ thuật viên thực hành kỹ thuật nuôi cấy, phân lập và kiểm soát vi sinh.

Môi trường PDA là “người đồng hành” tin cậy cho bất kỳ nhà vi sinh học nào đang nghiên cứu về thế giới nấm. Từ đặc tính giàu dinh dưỡng đến tính ổn định cao, PDA giúp hiện thực hóa các quan sát hình thái học một cách rõ nét nhất. Bên cạnh đó, việc kết hợp các giải pháp công nghệ hiện đại như thiết bị lên men trong nghiên cứu vi sinh hoặc hệ thống lọc tiếp tuyến trong quá trình tách lọc sinh học sẽ giúp nâng cao hiệu quả sản xuất và kiểm soát chất lượng.
Liên hệ MT để được tư vấn giải pháp công nghệ phù hợp cho phòng lab và nhà máy của bạn ngay hôm nay!
Thông tin liên hệ:
- Hotline: 0767 067 567
- Địa chỉ: TK40/10 Đường Trần Hưng Đạo, Phường Cầu Ông Lãnh, Thành phố Hồ Chí Minh, Việt Nam.
- Email: infor@mtenequip.com



